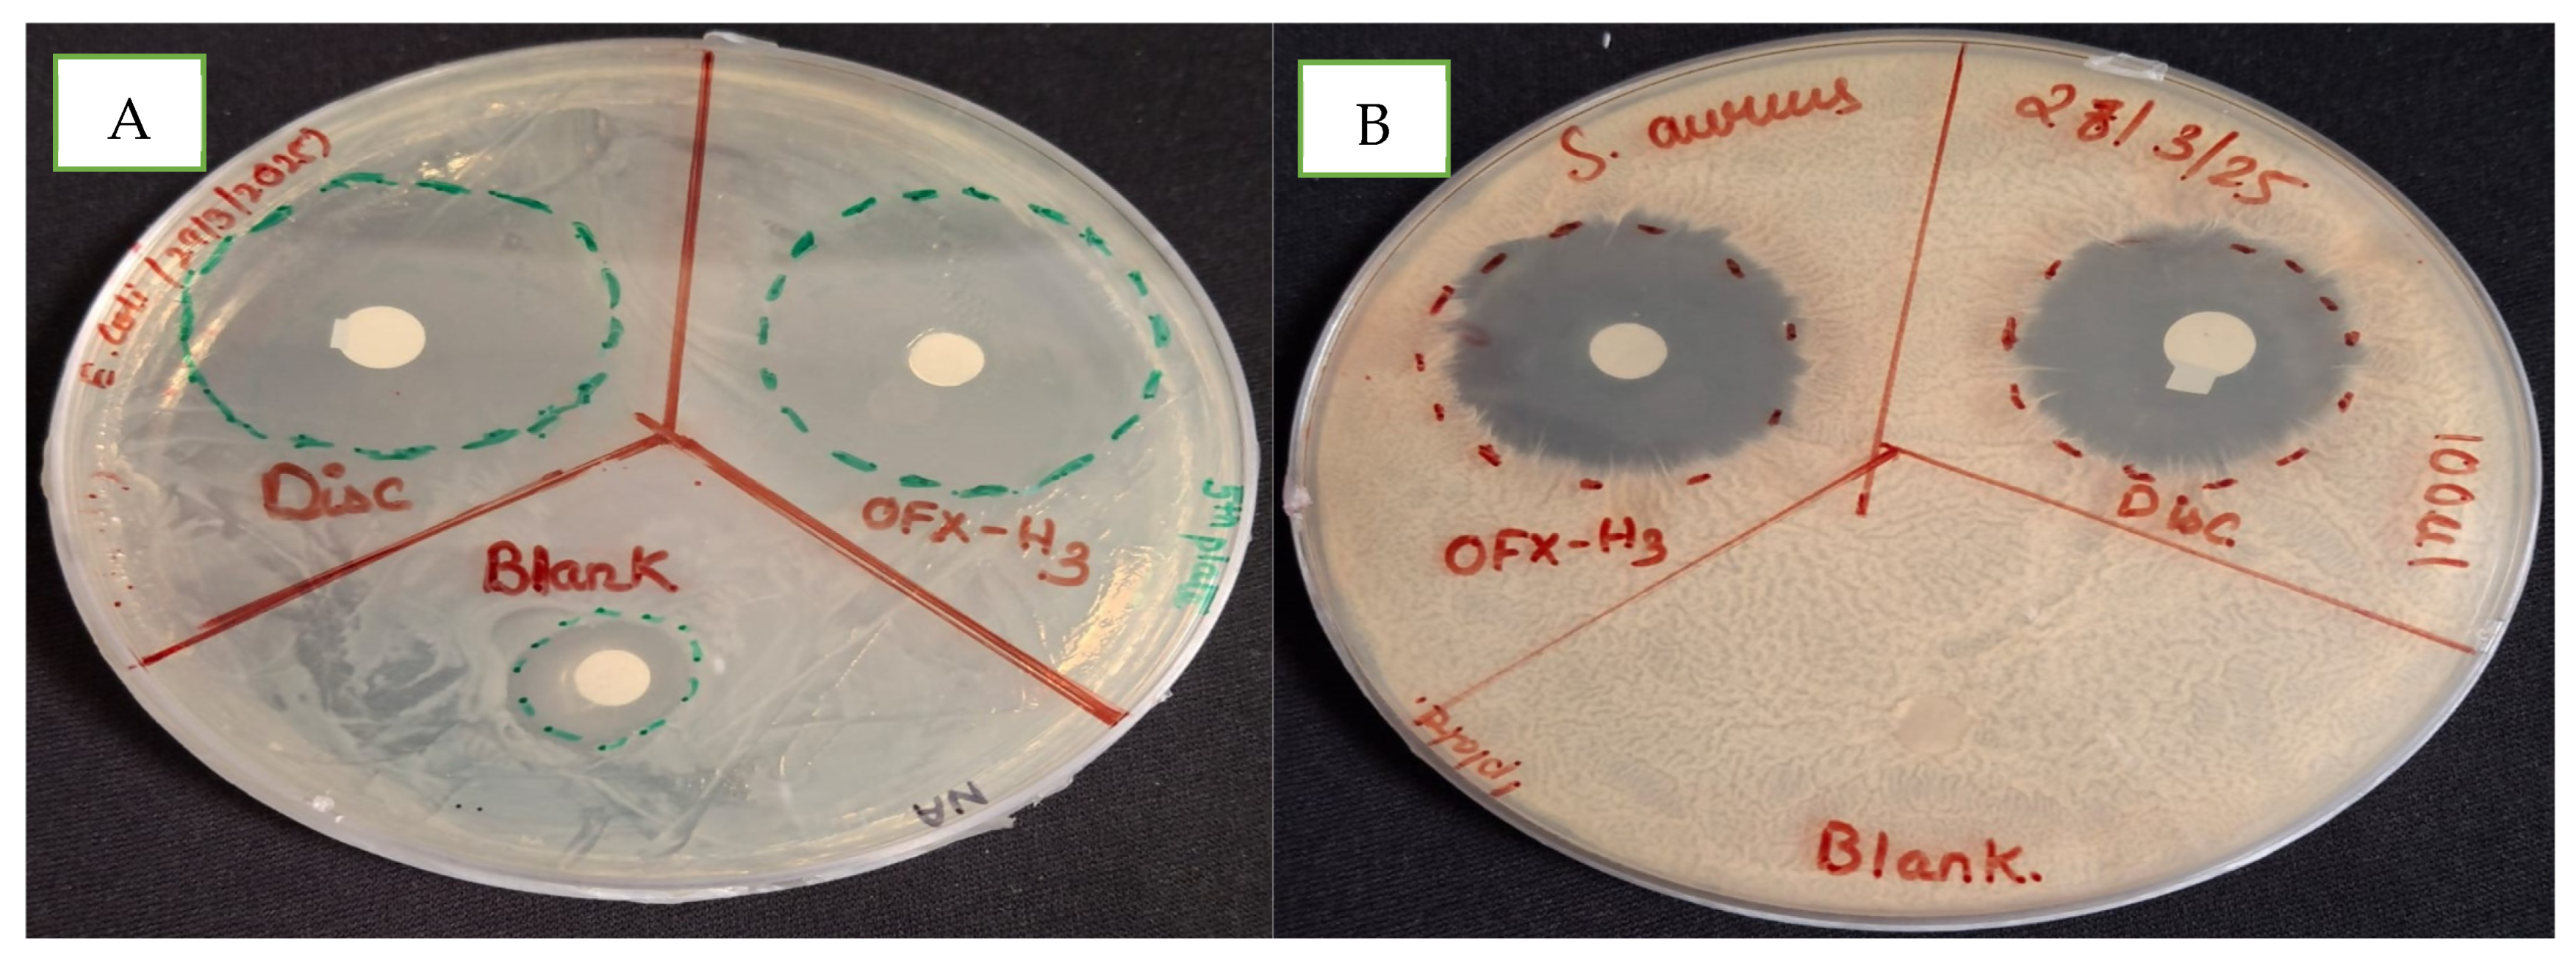
Ddc 04 00017 g006

Development of Ofloxacin-Loaded CS/PVA Hydrogel for the Treatment of Metritis in Bovine
Abstract
1. Introduction
2. Results and Discussion
2.1. Organoleptic Assay
2.2. Gel Fraction
2.3. Porosity
2.4. Swelling Ratio
2.5. Morphological Analysis of Hydrogel
2.6. Structural Analysis by FTIR, DSC and XRD
2.7. Mechanical Analysis by Viscosity Test
2.8. Entrapment Efficiency
2.9. In-Vitro Drug Release and Kinetics
2.10. In Vitro Antimicrobial Study
2.11. In Vivo Study
2.11.1. Effect of Treatment on Bacterial Load of Cervicovaginal Mucus
2.11.2. Bacterial Identification and Isolation
2.11.3. Rectum Temperature and pH of Vaginal Mucus
2.11.4. Cytology for Diagnosis of Subclinical Metritis
2.11.5. Statistical Analysis
3. Materials and Methods
3.1. Materials
3.2. Methods
3.2.1. Preparation of Hydrogel
3.2.2. Organoleptic Study
3.2.3. Gel Fraction
3.2.4. Porosity
3.2.5. Swelling Behaviour
3.2.6. Morphological Analysis
3.2.7. Physiochemical Analysis
Fourier Transform Infrared Spectroscopy
DSC
X-Ray Diffraction
3.2.8. Mechanical Analysis
Rheology (Viscosity)
3.2.9. Entrapment Efficiency
3.2.10. Drug Release and Kinetics
3.2.11. In Vitro Microbial Study
3.2.12. In-Vivo Study
Animal Management
Treatment and Sampling
Isolation and Identification of Bacteria
Rectum Temperature and pH of Vaginal Mucus
Cytology for Diagnosis of Subclinical Endometritis
4. Conclusions
Author Contributions
Funding
Institutional Review Board Statement
Informed Consent Statement
Data Availability Statement
Acknowledgments
Conflicts of Interest
Abbreviations
| PVA | Poly(vinyl alcohol) |
| CS | Chitosan |
| OFX | Ofloxacin |
| DNA | Deoxyribonucleic acid |
| F-T cycles | Freeze–thaw cycles |
| DSC | Differential Scanning Calorimetry |
| FTIR | Fourier Transform Infrared Spectroscopy |
| XRD | X-Ray Diffraction |
| PBS | Phosphate buffer saline |
| S. aureus | Staphylococcus aureus |
| E. coli | Escherichia coli |
| CA | Control group |
| CMD | Cervical mucous discharge |
| MLA | MacConkey lactose agar |
| BHI | Brain heart infusion agar |
| SDA | Sabouraud dextrose agar |
| AI | Artificial insemination |
| CFU | Colony forming unit |
| CVM | Cervicovaginal mucus |
| °F | Degree Fahrenheit |
| SEM | Scanning electron microscopy |
References
- Negasee, K.A. Clinical Metritis and Endometritis in Diary Cattle: A Review. Vet. Med.-Open J. 2020, 5, 51–56. [Google Scholar] [CrossRef]
- Thulasiraman, S.; Thulasiraman, M.S.; Gunasekar, M.; Narayansamy, A.; Sampathkumar, K.U.; Kumar, R.; Alam, K. Uterine Infections/Metritis. In Periparturient Diseases of Cattle; Wiley: Hoboken, NJ, USA, 2024; pp. 135–151. [Google Scholar] [CrossRef]
- Sheldon, I.M.; Molinari, P.C.C.; Ormsby, T.J.R.; Bromfield, J.J. Preventing postpartum uterine disease in dairy cattle depends on avoiding, tolerating and resisting pathogenic bacteria. Theriogenology 2020, 150, 158–165. [Google Scholar] [CrossRef] [PubMed]
- Sheldon, I.M.; Owens, S.E. Postpartum uterine infection and endometritis in dairy cattle. Anim. Reprod. 2017, 14, 622–629. [Google Scholar] [CrossRef]
- Haimerl, P.; Heuwieser, W. Invited review: Antibiotic treatment of metritis in dairy cows: A systematic approach. J. Dairy Sci. 2014, 97, 6649–6661. [Google Scholar] [CrossRef]
- Adegbeye, M.J.; Adetuyi, B.O.; Igirigi, A.I.; Adisa, A.; Palangi, V.; Aiyedun, S.; Alvarado-Ramírez, E.R.; Elghandour, M.M.M.Y.; Molina, O.M.; Oladipo, A.A.; et al. Comprehensive insights into antibiotic residues in livestock products: Distribution, factors, challenges, opportunities, and implications for food safety and public health. Food Control. 2024, 163, 110545. [Google Scholar] [CrossRef]
- Kumari, P.; Goyal, A.K. Challenges and opportunities in intravesical drug delivery approaches for the treatment of lower urinary diseases. J. Drug Deliv. Sci. Technol. 2024, 100, 106110. [Google Scholar] [CrossRef]
- Giguère, S.; Dowling, P.M. Fluoroquinolones. In Antimicrobial Therapy in Veterinary Medicine; Wiley: Hoboken, NJ, USA, 2013; pp. 295–314. [Google Scholar] [CrossRef]
- Kumar, A.; Jain, S.K.; Mishra, D.K.; Gautam, R. Influence of Drug Properties and Routes of Drug Administration on Design of Sustained and Controlled Release Systems. In Novel Carrier Systems for Targeted and Controlled Drug Delivery; Springer Nature: Singapore, 2024; pp. 1–46. [Google Scholar] [CrossRef]
- van Staden, D.; Gerber, M.; Lemmer, H.J.R. The Application of Nano Drug Delivery Systems in Female Upper Genital Tract Disorders. Pharmaceutics 2024, 16, 1475. [Google Scholar] [CrossRef]
- Ahmed, E.M. Hydrogel: Preparation; characterization; applications: A review. J. Adv. Res. 2015, 6, 105–121. [Google Scholar] [CrossRef]
- Oh, G.W.; Kim, S.C.; Cho, K.J.; Ko, S.C.; Lee, J.M.; Yim, M.J.; Kim, K.W.; Kim, H.S.; Kim, J.Y.; Lee, D.S.; et al. Poly(vinyl alcohol)/chitosan hydrogel incorporating chitooligosaccharide-gentisic acid conjugate with antioxidant and antibacterial properties as a potential wound dressing. Int. J. Biol. Macromol. 2024, 255, 128047. [Google Scholar] [CrossRef]
- Suflet, D.M.; Popescu, I.; Pelin, I.M.; Ichim, D.L.; Daraba, O.M.; Constantin, M.; Fundueanu, G. Dual Cross-Linked Chitosan/PVA Hydrogels Containing Silver Nanoparticles with Antimicrobial Properties. Pharmaceutics 2021, 13, 1461. [Google Scholar] [CrossRef]
- Liang, X.; Zhong, H.-J.; Ding, H.; Yu, B.; Ma, X.; Liu, X.; Chong, C.-M.; He, J. Polyvinyl Alcohol (PVA)-Based Hydrogels: Recent Progress in Fabrication, Properties, and Multifunctional Applications. Polymers 2024, 16, 2755. [Google Scholar] [CrossRef] [PubMed]
- Eivazzadeh-Keihan, R.; Noruzi, E.B.; Mehrban, S.F.; Aliabadi, H.A.M.; Karimi, M.; Mohammadi, A.; Maleki, A.; Mahdavi, M.; Larijani, B.; Shalan, A.E. Review: The latest advances in biomedical applications of chitosan hydrogel as a powerful natural structure with eye-catching biological properties. J. Mater. Sci. 2022, 57, 3855–3891. [Google Scholar] [CrossRef]
- Pinto, C.; Méndez, L.; Camacho-Rodríguez, B.; Silva-Cote, I. Antibacterial PVA/Chitosan/alginate/Meropenem-based hydrogel as a potential therapeutic strategy for chronic ulcers infections. Int. J. Polym. Mater. Polym. Biomater. 2024, 73, 1021–1033. [Google Scholar] [CrossRef]
- Khan, A.; Andleeb, A.; Azam, M.; Tehseen, S.; Mehmood, A.; Yar, M. Aloe vera and ofloxacin incorporated chitosan hydrogels show antibacterial activity, stimulate angiogenesis and accelerate wound healing in full thickness rat model. J. Biomed. Mater. Res. Part B Appl. Biomater. 2023, 111, 331–342. [Google Scholar] [CrossRef] [PubMed]
- Zitouni, M.A.; Slimane, S.B.K. Preparation and Characterization of Hydrogels Based on Chitsoan/Polyvinyl Alcohol Blends. Adv. Mater. Res. 2015, 1105, 203–207. [Google Scholar] [CrossRef]
- Khairan, K.; Hasan, M.; Idroes, R.; Diah, M. Fabrication and Evaluation of Polyvinyl Alcohol/Corn Starch/Patchouli Oil Hydrogel Films Loaded with Silver Nanoparticles Biosynthesized in Pogostemon cablin Benth Leaves’ Extract. Molecules 2023, 28, 2020. [Google Scholar] [CrossRef]
- Khorasani, M.T.; Joorabloo, A.; Adeli, H.; Mansoori-Moghadam, Z.; Moghaddam, A. Design and optimization of process parameters of polyvinyl (alcohol)/chitosan/nano zinc oxide hydrogels as wound healing materials. Carbohydr. Polym. 2019, 207, 542–554. [Google Scholar] [CrossRef]
- Farazin, A.; Mohammadimehr, M.; Ghasemi, A.H.; Naeimi, H. Design; preparation, and characterization of CS/PVA/SA hydrogels modified with mesoporous Ag2O/SiO2 and curcumin nanoparticles for green, biocompatible, and antibacterial biopolymer film. RSC Adv. 2021, 11, 32775–32791. [Google Scholar] [CrossRef]
- Lin, S.-P.; Lo, K.-Y.; Tseng, T.-N.; Liu, J.-M.; Shih, T.-Y.; Cheng, K.-C. Evaluation of PVA/dextran/chitosan hydrogel for wound dressing. Cell. Polym. 2019, 38, 15–30. [Google Scholar] [CrossRef]
- Long, J.; Etxeberria, A.E.; Kornelsen, C.; Nand, A.V.; Ray, S.; Bunt, C.R.; Seyfoddin, A. Development of a Long-Term Drug Delivery System with Levonorgestrel-Loaded Chitosan Microspheres Embedded in Poly(vinyl alcohol) Hydrogel. ACS Appl. Bio Mater. 2019, 2, 2766–2779. [Google Scholar] [CrossRef]
- Shahzadi, U.; Zeeshan, R.; Tabassum, S.; Khadim, H.; Arshad, M.; Ansari, A.A.; Safi, S.Z.; Haq, R.I.U.; Asif, A. Physico-chemical properties and in-vitro biocompatibility of thermo-sensitive hydrogel developed with enhanced antimicrobial activity for soft tissue engineering. Polym. Adv. Technol. 2023, 34, 3870–3884. [Google Scholar] [CrossRef]
- Dolezel, R.; Dolezel, T.R.; Palenik, T.; Cech, S.; Kohoutova, L.; Vyskocil, M. Bacterial contamination of the uterus in cows with various clinical types of metritis and endometritis and use of hydrogen peroxide for intrauterine treatment. Vet. Med. 2010, 55, 504–511. [Google Scholar] [CrossRef]
- Vickers, L.A.; Burfeind, O.; von Keyserlingk, M.A.G.; Veira, D.M.; Weary, D.M.; Heuwieser, W. Technical note: Comparison of rectal and vaginal temperatures in lactating dairy cows. J. Dairy Sci. 2010, 93, 5246–5251. [Google Scholar] [CrossRef]
- Jeon, S.J.; Ma, Z.; Kang, M.; Galvão, K.N.; Jeong, K.C. Application of chitosan microparticles for treatment of metritis and in vivo evaluation of broad spectrum antimicrobial activity in cow uteri. Biomaterials 2016, 110, 71–80. [Google Scholar] [CrossRef]
- Kasimanickam, R.; Duffield, T.; Foster, R.; Gartley, C.; Leslie, K.; Walton, J.; Johnson, W. Endometrial cytology and ultrasonography for the detection of subclinical endometritis in postpartum dairy cows. Theriogenology 2004, 62, 9–23. [Google Scholar] [CrossRef] [PubMed]
- Garnica-Palafox, I.M.; Estrella-Monroy, H.O.; Benítez-Martínez, J.A.; Bizarro, M.; Sánchez-Arévalo, F.M. Influence of Genipin and Multi-walled Carbon Nanotubes on the Dye Capture Response of CS/PVA Hybrid Hydrogels. J. Polym. Environ. 2022, 30, 4690–4709. [Google Scholar] [CrossRef]
- Figueroa-Pizano, M.D.; Vélaz, I.; Peñas, F.J.; Zavala-Rivera, P.; Rosas-Durazo, A.J.; Maldonado-Arce, A.D.; Martínez-Barbosa, M.E. Effect of freeze-thawing conditions for preparation of chitosan-poly (vinyl alcohol) hydrogels and drug release studies. Carbohydr. Polym. 2018, 195, 476–485. [Google Scholar] [CrossRef] [PubMed]
- Rynkowska, E.; Fatyeyeva, K.; Kujawa, J. Chemically and Thermally Crosslinked PVA-Based Membranes: Effect on Swelling and Transport Behavior. Polymers 2019, 11, 1799. [Google Scholar] [CrossRef]
- Vo, T.M.; Piroonpan, T.; Preuksarattanawut, C.; Kobayashi, T.; Potiyaraj, P. Characterization of pH-responsive high molecular-weight chitosan/poly (vinyl alcohol) hydrogel prepared by gamma irradiation for localizing drug release. Bioresour. Bioprocess. 2022, 9, 89. [Google Scholar] [CrossRef]
- Rizwan, M.; Rizwan, R.M.; Yahya, R.; Hassan, A.; Yar, M.; Azzahari, A.D.; Selvanathan, V.; Sonsudin, F.; Abouloula, C.N. pH sensitive hydrogels in drug delivery: Brief history, properties, swelling, and release mechanism, material selection and applications. Polymers 2017, 9, 137. [Google Scholar] [CrossRef]
- Farid, O.; Farid, F.O.; Mansour, F.; Habib, M.; Robinson, J.; Tarleton, S. Investigating the sorption influence of poly(vinyl alcohol) (PVA) at different crosslinking content. J. Environ. Chem. Eng. 2016, 4, 293–298. [Google Scholar] [CrossRef]
- Bi, S.; Wang, P.; Hu, S.; Li, S.; Pang, J.; Zhou, Z.; Sun, G.; Huang, L.; Cheng, X.; Xing, S.; et al. Construction of physical-crosslink chitosan/PVA double-network hydrogel with surface mineralization for bone repair. Carbohydr. Polym. 2019, 224, 115176. [Google Scholar] [CrossRef] [PubMed]
- Khan, S.; Khan, N.M.S.; Ranjha, N.M. Effect of degree of cross-linking on swelling and on drug release of low viscous chitosan/poly(vinyl alcohol) hydrogels. Polym. Bull. 2014, 71, 2133–2158. [Google Scholar] [CrossRef]
- Rade, P.P.; Garnaik, B. Ofloxacin-Loaded PLLA Nanofibrous Mats for Wound Dressing Applications. ACS Appl. Bio Mater. 2020, 3, 6648–6660. [Google Scholar] [CrossRef]
- Hyder, M.N.; Chen, P. Pervaporation dehydration of ethylene glycol with chitosan-poly(vinyl alcohol) blend membranes: Effect of CS-PVA blending ratios. J. Memb. Sci. 2009, 340, 171–180. [Google Scholar] [CrossRef]
- Sahoo, S.; Sahoo, C.K.S.; Chakraborti, C.K.; Mishra, S.C.; Nanda, U.N.; Naik, S. FTIR and XRD investigations of some fluoroquinolones. Int. J. Pharm. Pharm. Sci. 2011, 3, 165–170. [Google Scholar]
- Elashmawi, I.S.; Ismail, A.M.; Abdelghany, A.M. The incorporation of polypyrrole (PPy) in CS/PVA composite films to enhance the structural, optical, and the electrical conductivity. Polym. Bull. 2023, 80, 11379–11399. [Google Scholar] [CrossRef]
- Peng, L.; Zhou, Y.; Lu, W.; Zhu, W.; Li, Y.; Chen, K.; Zhang, G.; Xu, J.; Deng, Z.; Wang, D. Characterization of a novel polyvinyl alcohol/chitosan porous hydrogel combined with bone marrow mesenchymal stem cells and its application in articular cartilage repair. BMC Musculoskelet. Disord. 2019, 20, 257. [Google Scholar] [CrossRef]
- Tang, Y.F.; Du, Y.M.; Hu, X.W.; Shi, X.W.; Kennedy, J.F. Rheological characterisation of a novel thermosensitive chitosan/poly(vinyl alcohol) blend hydrogel. Carbohydr. Polym. 2007, 67, 491–499. [Google Scholar] [CrossRef]
- Varma, M.V.S.; Kaushal, A.M.; Garg, A.; Garg, S. Factors Affecting Mechanism and Kinetics of Drug Release from Matrix-Based Oral Controlled Drug Delivery Systems. Am. J. Drug Deliv. 2004, 2, 43–57. [Google Scholar] [CrossRef]
- Bowen, W.E.; Wang, Q.; Wuelfing, W.P.; Thomas, D.L.; Nelson, E.D.; Mao, Y.; Hill, B.; Thompson, M.; Gallagher, K.; Reed, R.A. A Biopharmaceutical Classification System Approach to Dissolution: Mechanisms and Strategies. In Biopharmaceutics Applications in Drug Development; Springer: Boston, MA, USA, 2008; pp. 290–316. [Google Scholar] [CrossRef]
- Askarizadeh, M.; Askarizadeh, N.M.; Esfandiari, N.; Honarvar, B.; Sajadian, S.A.; Azdarpour, A. Kinetic Modeling to Explain the Release of Medicine from Drug Delivery Systems. ChemBioEng Rev. 2023, 10, 1006–1049. [Google Scholar] [CrossRef]
- Sokker, H.H.; Ghaffar, A.M.A.; Gad, Y.H.; Aly, A.S. Synthesis and characterization of hydrogels based on grafted chitosan for the controlled drug release. Carbohydr. Polym. 2009, 75, 222–229. [Google Scholar] [CrossRef]
- Mekibib, B.; Belachew, M.; Asrade, B.; Abebe, R. Isolation; identification, and antibiogram profiles of bacteria from dairy cows with postpartum uterine infection in southern Ethiopia. Res. Sq. 2023. [Google Scholar] [CrossRef]
- Basak, S.; Shetty, P.H. Conventional Microbial Counting and Identification Techniques. In Techniques to Measure Food Safety and Quality; Springer International Publishing: Cham, Switzerland, 2021; pp. 69–89. [Google Scholar] [CrossRef]
- Scott, H.M.; Atkins, G.; Willows, B.; McGregor, R. Effects of 2 commercially-available 9-way killed vaccines on milk production and rectal temperature in Holstein-Friesian dairy cows. Can. Vet. J. 2001, 42, 793–798. [Google Scholar]

| Code | Ratio PVA: CS | Resemblance | Consistency | Colour | Readability | Homogeneity |
|---|---|---|---|---|---|---|
| H1 | 9:1 | Translucent, slightly cloudy | Smooth, fluid-like | Whitish | Relatively clear | Homogeneous |
| H2 | 8:2 | Translucent, slightly cloudy | Smooth, semifluid | Whitish | Moderately clear | Homogeneous |
| H3 | 7:3 | Cloudy | Soft, semi-gel-like | Whitish | Mildly opaque | Homogeneous |
| H4 | 6:4 | Cloudy, with visible thickening | Gel-like, slightly firmer | Whitish | Opaque | Homogeneous |
| H5 | 5:5 | Cloudy, thick and gel-like | Firm, gel-like | Whitish | Highly opaque | Homogeneous |
Disclaimer/Publisher’s Note: The statements, opinions and data contained in all publications are solely those of the individual author(s) and contributor(s) and not of MDPI and/or the editor(s). MDPI and/or the editor(s) disclaim responsibility for any injury to people or property resulting from any ideas, methods, instructions or products referred to in the content. |
© 2025 by the authors. Licensee MDPI, Basel, Switzerland. This article is an open access article distributed under the terms and conditions of the Creative Commons Attribution (CC BY) license (https://creativecommons.org/licenses/by/4.0/).
Share and Cite
Kumari, P.; Shukla, M.K.; Tripathi, A.; Pandey, J.; Goyal, A.K. Development of Ofloxacin-Loaded CS/PVA Hydrogel for the Treatment of Metritis in Bovine. Drugs Drug Candidates 2025, 4, 17. https://doi.org/10.3390/ddc4020017
Kumari P, Shukla MK, Tripathi A, Pandey J, Goyal AK. Development of Ofloxacin-Loaded CS/PVA Hydrogel for the Treatment of Metritis in Bovine. Drugs and Drug Candidates. 2025; 4(2):17. https://doi.org/10.3390/ddc4020017
Chicago/Turabian StyleKumari, Priyanka, Manish Kumar Shukla, Ashutosh Tripathi, Janmejay Pandey, and Amit K. Goyal. 2025. "Development of Ofloxacin-Loaded CS/PVA Hydrogel for the Treatment of Metritis in Bovine" Drugs and Drug Candidates 4, no. 2: 17. https://doi.org/10.3390/ddc4020017
APA StyleKumari, P., Shukla, M. K., Tripathi, A., Pandey, J., & Goyal, A. K. (2025). Development of Ofloxacin-Loaded CS/PVA Hydrogel for the Treatment of Metritis in Bovine. Drugs and Drug Candidates, 4(2), 17. https://doi.org/10.3390/ddc4020017

